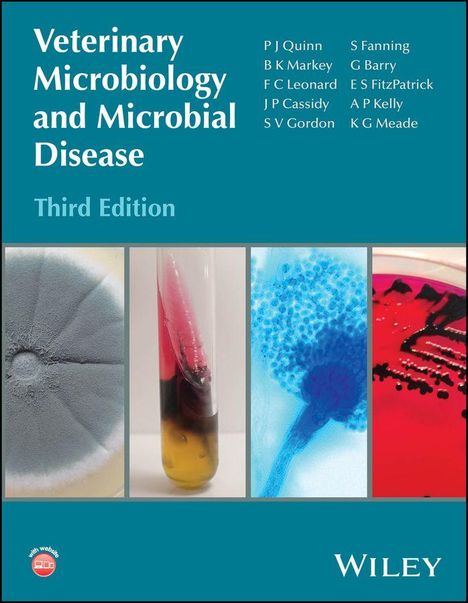
Titel: Veterinary Microbiology and Microbial Disease, Third Edition. Autoren: P J Quinn, B K Markey, F C Leonard, und andere. Das Cover zeigt vier mikroskopische Aufnahmen von Mikroben und Bakterien, darunter ein Schimmelpilz und Probenröhrchen.

A. P. Kelly: Veterinary Microbiology and Microbial Disease, Gebunden
Veterinary Microbiology and Microbial Disease
(soweit verfügbar beim Lieferanten)
- Verlag:
- John Wiley & Sons Inc, 05/2026
- Einband:
- Gebunden
- Sprache:
- Englisch
- ISBN-13:
- 9781119716785
- Artikelnummer:
- 12623320
- Umfang:
- 1008 Seiten
- Nummer der Auflage:
- 26003
- Ausgabe:
- 3. Auflage
- Gewicht:
- 2994 g
- Maße:
- 279 x 218 mm
- Stärke:
- 48 mm
- Erscheinungstermin:
- 7.5.2026
- Hinweis
-
Achtung: Artikel ist nicht in deutscher Sprache!
Klappentext
The definitive resource for understanding infectious disease in veterinary medicine
The revised third edition of Veterinary Microbiology and Microbial Disease equips veterinary professionals with essential knowledge of bacteriology, mycology and virology. Serving as both an authoritative reference and practical clinical guide to infectious disease, the authors provide up-to-date information relevant to animal and public health, along with the latest diagnostic tools and the information required to treat and control them.
This new edition incorporates substantial advances in molecular biology and genome sequencing that have transformed veterinary microbiology. New material also addresses contemporary challenges in infectious disease management, such as drug-resistant microorganisms, zoonotic pathogens, and other emerging threats.
Readers will find:
- Expanded coverage of molecular diagnostic methods and genome sequencing for pathogen identification and characterization
- Comprehensive analysis of antibacterial resistance mechanisms, multiple drug resistance patterns, and their implications for zoonotic and nosocomial pathogens
- Updated taxonomy of important pathogens in line with the recommendations of international committees
- Colour photographs illustrating important grossly- and microscopically-visible responses to infectious agents
- A fully revised section on the interactions of microbial pathogens with animal body systems to facilitate a systematic approach to investigating the role of infectious agents in disease production and differential diagnosis
- Access to a companion website providing all figures from the text as downloadable slides for educational use
Veterinary Microbiology and Microbial Disease provides undergraduate and postgraduate veterinary students, practicing veterinary surgeons, researchers, and graduates specializing in diagnostic microbiology or regulatory activities with up-to-date information on bacterial, fungal, and viral pathogens.